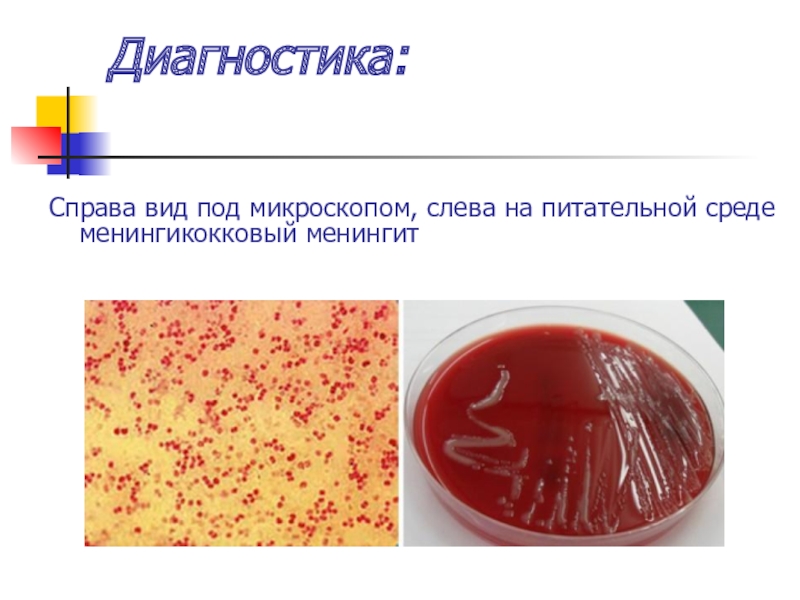

Шурупцева Ю.В.
- Главная
- Разное
- Образование
- Спорт
- Естествознание
- Природоведение
- Религиоведение
- Французский язык
- Черчение
- Английский язык
- Астрономия
- Алгебра
- Биология
- География
- Геометрия
- Детские презентации
- Информатика
- История
- Литература
- Математика
- Музыка
- МХК
- Немецкий язык
- ОБЖ
- Обществознание
- Окружающий мир
- Педагогика
- Русский язык
- Технология
- Физика
- Философия
- Химия
- Шаблоны, фоны, картинки для презентаций
- Экология
- Экономика
Презентация, доклад на тему Презинтация по МДК 02.05 Сестринская помощь при инфекционных болезнях на тему Менингококковая инфекция
Содержание
- 1. Презинтация по МДК 02.05 Сестринская помощь при инфекционных болезнях на тему Менингококковая инфекция
- 2. Менингококковая инфекция -антропонозная бактериальная болезнь с воздушно-капельным
- 3. Этиология: Возбудитель менингококк, под микроскопом имеет
- 4. Эпидемиология: Антропоноз, источник – больной острой формой
- 5. Эпидемиология:
- 6. Клиника: Инкубационный период от 2 до 10
- 7. Клиника: Менингококковый назафарингит характеризуется развитием катарального воспаления
- 8. Клиника: Менингококковыйназафарингит
- 9. Клиника: Менингит развивается остро без продромального периода
- 10. Клиника: Рвота без тошноты, внезапно, не приносящая
- 11. Клиника: Поражение ЦНС, появление менингиальных симптомов, которые
- 12. Клиника:
- 13. Клиника:
- 14. Клиника: Характерная поза для больного: на боку,
- 15. Клиника: Клиника менингита обусловлена воспалением мягких оболочек мозговой гиперпродукции спинномозговой жидкости, нарушении оттока.
- 16. Клиника: Менингококцемия протекает с выраженным интоксикационным синдромом,
- 17. Клиника: Менингококцемия
- 18. Клиника: Заболевание осложняется инфекционно-токсическим шоком, синдромом отека-набухания головного мозга, острой надпочечниковой недостаточностью.
- 19. Осложнения
- 20. Диагностика: Специфическая клиника, бактериологические и серологические методы.Бактериологический
- 21. Диагностика: кровь больного или спинномозговая жидкость
- 22. Диагностика: Справа вид под микроскопом, слева на питательной среде менингикокковый менингит
- 23. Диагностика: слева - вид ликвора при менингококковом менингите, справа бактериоскопия из спинномозговой жидкости
- 24. Диагностика: Приготовление мазков толстой капли. В препарате
- 25. Диагностика: Серологические исследования используются для выявления антител
- 26. Диагностика: РНГА – реакция непрямой гемоаглютинации
- 27. Диагностика: Методика ПЦР(полимеразная цепная реакция) является высокоспецифичной
- 28. Диагностика: В последнее время для выявления специфических
- 29. Лечение: Назофарингит:Этиотропная терапия.Частое полоскание ротоглотки антисептиком: Фурацилин,
- 30. Профилактика: Вакцинопрофилактика. В России при проведении прививок
- 31. Профилактика: Вакцины - моно А и дивакцина А+С
- 32. Профилактика: Поливалентная вакцина Менцевакс ACWY фирмы «ГлаксоСмитКляйн, Бельгия»
- 33. Профилактика: Пассивная экстренная иммунизацияПри выявлении у больного
- 34. Уход: Больным локализованными формами в острый период
- 35. Противоэпидемические мероприятия в очаге:1. Определяется круг контактных
- 36. Противоэпидемические мероприятия в очаге:5. Члены семьи больного,
- 37. Противоэпидемические мероприятия в очаге:9. Контактные лица дважды
- 38. Спасибо за внимание!!!
Менингококковая инфекция -антропонозная бактериальная болезнь с воздушно-капельным путем заражения, протекает в разнообразных клинических формах – от бактерионосительства до меннингоэнцефалита и сепсиса.
Слайд 1Менингококковая инфекция
ГОСУДАРСТВЕННОЕ АВТОНОМНОЕ ПРОФЕССИОНАЛЬНОЕ ОБРАЗОВАТЕЛЬНОЕ УЧРЕЖДЕНИЕ САРАТОВСКОЙ ОБЛАСТИ
«БАЛАШОВСКИЙ МЕДИЦИНСКИЙ КОЛЛЕДЖ»
Выполнила: преподаватель
Слайд 2Менингококковая инфекция -
антропонозная бактериальная болезнь с воздушно-капельным путем заражения, протекает в
разнообразных клинических формах – от бактерионосительства до меннингоэнцефалита и сепсиса.
Слайд 3Этиология:
Возбудитель менингококк, под микроскопом имеет вид кофейного или бобового зерна,
неподвижен, спор не образует, строгий аэроб. Чувствителен к факторам внешней среды – быстро погибает под действием солнечного света, высушивании, воздействии дезинфицирующих средств. В организме человека размножается как вне клеток, так и внутри клеток, погибая выделяет эндотоксин.
Слайд 4Эпидемиология:
Антропоноз, источник – больной острой формой или бактерионоситель. Механизм передачи аэрогенный,
воздушно-капельный. Чаще болеют дети, подростки. Сезонность зимне-весенняя. Иммунитет стойкий.
Слайд 6Клиника:
Инкубационный период от 2 до 10 дней.
Выделяют следующие формы болезни:
Локализованные –
бактерионосительство, острый назофарингит, пневмония;
Генерализованные – менингококковый сепсис, или меннингококцемия, менингит, менингоэнцефалит, смешанная и редкие формы болезни (эндокардит, артрит, иридоциклит).
Генерализованные – менингококковый сепсис, или меннингококцемия, менингит, менингоэнцефалит, смешанная и редкие формы болезни (эндокардит, артрит, иридоциклит).
Слайд 7Клиника:
Менингококковый назафарингит характеризуется развитием катарального воспаления слизистой оболочки носа и глотки,
увеличением переднешейных лимфатических узлов, умеренно выраженной интоксикации с повышением температуры тела 37,5-38,5ºС. Головная боль, головкружение. Склеры, конъюнктивы инфицированы, слизистая носа отечна. Лёгкая гиперемия миндальных дужек, мягкого неба. Яркая гиперемия и отек задней стенки глотки, часто на ней экссудат.
Слайд 9Клиника:
Менингит развивается остро без продромального периода (если за него не принимать
назафарингит) температура 38-40ºС и выше с резким ознобом, температурная кривая неправильного типа, резкая общая слабость, боль в глазах особенно при движении.
Головная боль: исключительно сильная, мучительная, быстро нарастающая, давящая или распирающая без определенной локализации, усиливающаяся при перемени положения тела, резком звуке, ярком свете.
Головная боль: исключительно сильная, мучительная, быстро нарастающая, давящая или распирающая без определенной локализации, усиливающаяся при перемени положения тела, резком звуке, ярком свете.
Слайд 10Клиника:
Рвота без тошноты, внезапно, не приносящая облегчение, обильная, повторяющаяся. Резко повышена
чувствительность к внешним раздражителям (гиперстезии) – свет, звук, запах, прикосновение.
С первых часов у большинства больных возникает судороги, нарушение сознания в плоть до потери.
Кожа сухая, в первые сутки на ней могут быть экзантема, разеолезно-папулезная, которая быстро исчезает и бесследно, на 3-4 день часто появляется герпес.
Тахикардия, пульс слабого наполнения, АД снижено, тоны сердца приглушены, часто аритмия.
Язык густо обложен, сухой. Живот втянут, чаще задержка стула, олигоурия.
С первых часов у большинства больных возникает судороги, нарушение сознания в плоть до потери.
Кожа сухая, в первые сутки на ней могут быть экзантема, разеолезно-папулезная, которая быстро исчезает и бесследно, на 3-4 день часто появляется герпес.
Тахикардия, пульс слабого наполнения, АД снижено, тоны сердца приглушены, часто аритмия.
Язык густо обложен, сухой. Живот втянут, чаще задержка стула, олигоурия.
Слайд 11Клиника:
Поражение ЦНС, появление менингиальных симптомов, которые появляются с первого дня и
быстро прогрессируют:
регидность затылочных мышц – при попытки привести подбородок к грудине, невозможность из-за сопротивления затылочных мышц;
симптом Кернига – распрямление, когда нога согнута в тазобедренном суставе, вызывает резкое сопротивление сгибателей голени и усиливает головную боль;
симптом Брудзинского: верхний (голову пытаются привести к грудине, сгибаются ноги в коленях); средний (надавлиние кулаком на лобок, ноги сгибаются в коленях); нижний (сгибаем к животу одну ногу, автоматически сгибается вторая);
- симптом Менделя: при надавливании на переднюю стенку наружного слухового прохода, резкая болезненность и гримаса, даже в бессознательном состоянии.
регидность затылочных мышц – при попытки привести подбородок к грудине, невозможность из-за сопротивления затылочных мышц;
симптом Кернига – распрямление, когда нога согнута в тазобедренном суставе, вызывает резкое сопротивление сгибателей голени и усиливает головную боль;
симптом Брудзинского: верхний (голову пытаются привести к грудине, сгибаются ноги в коленях); средний (надавлиние кулаком на лобок, ноги сгибаются в коленях); нижний (сгибаем к животу одну ногу, автоматически сгибается вторая);
- симптом Менделя: при надавливании на переднюю стенку наружного слухового прохода, резкая болезненность и гримаса, даже в бессознательном состоянии.
Слайд 14Клиника:
Характерная поза для больного: на боку, голова запрокинута, ноги согнуты в
коленях и тазобедренных суставах и приведены к животу («поза легавой собаки»).
Слайд 15Клиника:
Клиника менингита обусловлена воспалением мягких оболочек мозговой гиперпродукции спинномозговой жидкости, нарушении
оттока.
Слайд 16Клиника:
Менингококцемия протекает с выраженным интоксикационным синдромом, распространенной геморрагической сыпью и часто
с внутренними кровотечениями.
Спустя 10-14 часов от начала заболевания на коже нижних конечностей, затем верхних конечностей, позднее на туловище появляются характерная «звездчатая» сыпь с быстрым развитием некрозов в крупных элементов экзантемы.
Встречаются некрозы кончиков пальцев кистей, стоп, ушных раковин и т.д.
Спустя 10-14 часов от начала заболевания на коже нижних конечностей, затем верхних конечностей, позднее на туловище появляются характерная «звездчатая» сыпь с быстрым развитием некрозов в крупных элементов экзантемы.
Встречаются некрозы кончиков пальцев кистей, стоп, ушных раковин и т.д.
Слайд 18Клиника:
Заболевание осложняется инфекционно-токсическим шоком, синдромом отека-набухания головного мозга, острой надпочечниковой недостаточностью.
Слайд 20Диагностика:
Специфическая клиника, бактериологические и серологические методы.
Бактериологический метод: бактериологический посев, материалом служат
– носоглоточная слизь, кровь, спинномозговая жидкости.
Серологические методы: РНГА, ИФА, ПЦР.
Серологические методы: РНГА, ИФА, ПЦР.
Слайд 22Диагностика:
Справа вид под микроскопом, слева на питательной среде менингикокковый менингит
Слайд 23Диагностика:
слева - вид ликвора при менингококковом менингите, справа бактериоскопия из спинномозговой
жидкости
Слайд 24Диагностика:
Приготовление мазков толстой капли. В препарате (фото справа) видны менингококки, окрашенные
в темно-синий цвет (окраска метиленовым синим).
Слайд 25Диагностика:
Серологические исследования используются для выявления антител в организме человека, вырабатываемых против
антигенов менингококков. Данная методика используется для ретроспективной диагностики и применяется с интервалом от 7 до 12 дней. С целью обнаружения антигенов возбудителя используются реакции агглютинации.
Слайд 27Диагностика:
Методика ПЦР(полимеразная цепная реакция) является высокоспецифичной и позволяет выявлять ДНК бактерий,
даже если их в исследуемом материале несколько десятков и даже единиц.
Слайд 28Диагностика:
В последнее время для выявления специфических антител в крови больного или
спинномозговой жидкости стали применяться экспресс-методики:
методика иммунофлюоресценции,
реакция энзиммеченых антител,
реакция преципитации в геле,
иммуноэлектрофорез с групповыми преципитирующими антисыворотками,
методика встречного иммуноэлектрофореза (ВИЭФ),
иммуноферментный анализ (ИФА),
радиоиммунологические методы.
методика иммунофлюоресценции,
реакция энзиммеченых антител,
реакция преципитации в геле,
иммуноэлектрофорез с групповыми преципитирующими антисыворотками,
методика встречного иммуноэлектрофореза (ВИЭФ),
иммуноферментный анализ (ИФА),
радиоиммунологические методы.
Слайд 29Лечение:
Назофарингит:
Этиотропная терапия.
Частое полоскание ротоглотки антисептиком: Фурацилин, Борная кислота.
Симптоматические средства.
Режим палатный. Обильно,
частое, теплое, витаминное питье.
Диета № 15.
Менингит:
Этиотропная терапия.
Дезинтоксикационная терапия.
Дегидрационная терапия (методом форсированного диуреза).
Режим постельный, питание чаще зондовое или парнтеральное.
Менингококкемия:
Этиотропная терапия: вначале бактериостатики + терапия против ИТШ, когда исчезает угроза шока, назначают бактериолитики.
Сердечно-сосудистые средства.
Гормональная терапия.
Постельный режим.
Диета № 15.
Менингит:
Этиотропная терапия.
Дезинтоксикационная терапия.
Дегидрационная терапия (методом форсированного диуреза).
Режим постельный, питание чаще зондовое или парнтеральное.
Менингококкемия:
Этиотропная терапия: вначале бактериостатики + терапия против ИТШ, когда исчезает угроза шока, назначают бактериолитики.
Сердечно-сосудистые средства.
Гормональная терапия.
Постельный режим.
Слайд 30Профилактика:
Вакцинопрофилактика.
В России при проведении прививок от менингококковой инфекции применяются следующие
виды вакцин:
вакцины отечественные моно А и дивакцина А+С,
вакцина менинго А+С фирмы «Авентис Пастер»,
поливалентная вакцина Менцевакс ACWY фирмы «ГлаксоСмитКляйн, Бельгия»
вакцины отечественные моно А и дивакцина А+С,
вакцина менинго А+С фирмы «Авентис Пастер»,
поливалентная вакцина Менцевакс ACWY фирмы «ГлаксоСмитКляйн, Бельгия»
Слайд 33Профилактика:
Пассивная экстренная иммунизация
При выявлении у больного менингококков, серогруппа которых не соответствует
вакцинам, контактным лицам вводится нормальный иммуноглобулин в срок не позже 7-и дней от момента выявления первого больного с генерализованной формой заболевания
Слайд 34Уход:
Больным локализованными формами в острый период необходимо обеспечить механически, термически, химически
щадащую диету, регулярно контролировать полоскание горла антисептическими средствами.
Больные генерализованными формами нуждаются в тщательном уходе, направленном на предупреждение аспирации рвотными массами, мацерации кожи и пролежней, гипостатической пневмонии. Необходимо поддерживать строгие асептические условия в области внутрисосудистых катетеров, проводить регулярную смену белья, в особенности случаях нарушения сознания больного, обеспечить правильный режим питания. В помещениях должен соблюдаться комфортный температурный режим, препятствующий переохлаждению пациентов.
Больные генерализованными формами нуждаются в тщательном уходе, направленном на предупреждение аспирации рвотными массами, мацерации кожи и пролежней, гипостатической пневмонии. Необходимо поддерживать строгие асептические условия в области внутрисосудистых катетеров, проводить регулярную смену белья, в особенности случаях нарушения сознания больного, обеспечить правильный режим питания. В помещениях должен соблюдаться комфортный температурный режим, препятствующий переохлаждению пациентов.
Слайд 35Противоэпидемические мероприятия в очаге:
1. Определяется круг контактных лиц и границы очага.
2.
В очаге менингококковой инфекции устанавливается карантин сроком на 10 дней.
3. В детских дошкольных учреждениях прекращается прием детей и переводы из группы в группу.
4. Проводится разъяснительная работа среди родителей. Родственникам, ухаживающим за больными детьми, предлагается ношение марлевых повязок.
3. В детских дошкольных учреждениях прекращается прием детей и переводы из группы в группу.
4. Проводится разъяснительная работа среди родителей. Родственникам, ухаживающим за больными детьми, предлагается ношение марлевых повязок.
Слайд 36Противоэпидемические мероприятия в очаге:
5. Члены семьи больного, дети и персонал дошкольных
учреждений проходят профилактическое лечение Рифампицином в течение 2-х дней.
6. Контактным лицам в первые 5 — 10 дней проводится экстренная вакцинация вакцинами, антигены которых соответствуют серогруппе менингококков, выявленных у больного.
7. При выявлении у больного менингококков, серогруппа которых не соответствует вакцинам, контактным лицам вводится нормальный иммуноглобулин.
8. За контактными лицами устанавливается медицинское наблюдение. Ежедневно осматривается носоглотка, слизистые оболочки и кожные покровы, измеряется температура тела.
6. Контактным лицам в первые 5 — 10 дней проводится экстренная вакцинация вакцинами, антигены которых соответствуют серогруппе менингококков, выявленных у больного.
7. При выявлении у больного менингококков, серогруппа которых не соответствует вакцинам, контактным лицам вводится нормальный иммуноглобулин.
8. За контактными лицами устанавливается медицинское наблюдение. Ежедневно осматривается носоглотка, слизистые оболочки и кожные покровы, измеряется температура тела.
Слайд 37Противоэпидемические мероприятия в очаге:
9. Контактные лица дважды с интервалом в 3
— 7 дней подлежат бактериологическому исследованию.
10. Носители менингококков изолируются. Они проходят курс антибиотикотерапии.
11. Больной с менингококковой инфекцией подлежит выписке из стационара при достижении клинического излечения и только после отрицательного результата бактериологического исследования, произведенного через 3 дня с момента отмены антибиотиков.
12. Лица, ранее перенесшие заболевание (реконвалисценты) допускаются в коллектив при условии получения одного отрицательного результата бактериологического исследования, проведенного через 5 дней после выздоровления.
13. Менингококки весьма чувствительны к факторам внешней среды и дезинфицирующим средствам, из-за чего заключительная дезинфекция в очаге инфекции после изоляции больного не проводится. Ежедневная влажная уборка, частое проветривание помещения, использование УФО и бактерицидных ламп, обеззараживание посуды и игрушек — достаточные меры профилактики
10. Носители менингококков изолируются. Они проходят курс антибиотикотерапии.
11. Больной с менингококковой инфекцией подлежит выписке из стационара при достижении клинического излечения и только после отрицательного результата бактериологического исследования, произведенного через 3 дня с момента отмены антибиотиков.
12. Лица, ранее перенесшие заболевание (реконвалисценты) допускаются в коллектив при условии получения одного отрицательного результата бактериологического исследования, проведенного через 5 дней после выздоровления.
13. Менингококки весьма чувствительны к факторам внешней среды и дезинфицирующим средствам, из-за чего заключительная дезинфекция в очаге инфекции после изоляции больного не проводится. Ежедневная влажная уборка, частое проветривание помещения, использование УФО и бактерицидных ламп, обеззараживание посуды и игрушек — достаточные меры профилактики